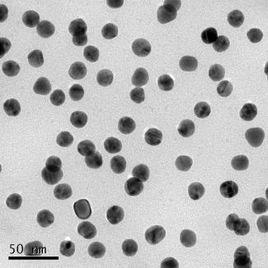
粒子凝膠

概述
離子凝膠是一種具有離子導電性的固態混合物,通常是由高分子有機聚合物和可電解為離子的鹽類電解質材料混合而成,因其聚合物分子鏈互相連線或纏繞,形成空間網狀結構,結構空隙中充滿了作為分散介質的陰陽離子,與傳統凝膠的結構相似,因而稱其為“離子凝膠”。 組成離子凝膠的高分子多為膠狀嵌段共聚物,共聚物會形成交聯的網狀結構,為離子凝膠提供了較高的拉伸強度,同時網狀結構也為離子的運動提供了通道。混合在高分子共聚物里的離子液為熔融態強電解質,這種強電解質在熔融態會以陰、陽離子的狀態存在與離子凝膠中。離子凝膠內部的電荷分布如圖 1-2 所示。由於共聚物的功能團有很多配位位點,所以在沒有外加電場的狀態下陰、陽離子大多以配位鍵與共聚物的功能團相連,分散在整個離子凝膠當中。而在外電場作用下,離子在聚合物鏈和離子配位位點之間的局部運動產生陰陽離子的遷移,從而在離子凝膠介電層內部產生不均勻的電荷分布,陰陽離子分別堆疊在介電層界面兩端,形成雙電層。
套用
除了能量存儲,離子凝膠在 OTFT 上的套用在近幾年來也受到了越來越多的關注和研究,在國外具有比較高的研究水平。為了提高 OTFT 在柔性電子領域的性能,特別需要一個高電容、可溶液法加工的介電材料作為 OTFT 的柵介電層。在 OTFT 體系中,金屬電極—介電層的兩相界面存在電勢,將產生雙電層。電極的金屬相為良導體,過剩電荷集中在表面;介電層的電阻較大,過剩電荷部分緊貼相界面,形成雙電層。一般 OTFT 絕緣層材料電荷不易移動,電荷在材料內部多呈分散態,因而很難形成雙電層。離子凝膠作為 OTFT 的柵介電層,在柵極電壓作用下會形成十分明顯的雙電層,其總厚度一般約為 0.2-20 nm,遠小於一般絕緣層的厚度,因而 OTFT 的離子凝膠柵介電層會表現出較大的電容,例如在微米級的厚度下,可以獲得 μF/cm2數量級的單位面積電容,遠遠高於普通的聚合物介電材料,從而能有效地降低 OTFT 開關所需要的電壓,並能顯著提高開態電流。
離子凝膠法是殼聚糖載藥微囊的一種新型製備方法。 它以三聚磷酸鈉為交聯劑,以 1%的醋酸為製備體系,通過TPP的負電荷和殼聚糖的正電荷相結合而形成微囊。 製備條件溫和,整個過程不使用任何對人體有害的制
劑,因此成為殼聚糖載藥微囊的理想製備方法之一。但是用該方法製備藥物微囊時影響因素較多,目前,對於最佳製備條件的研究尚屬初步探索階段。關於藥物所帶電荷對微囊包封率的影響尚未見報導, 本實驗以牛血清白蛋白為模型藥物探索確立微囊的最佳製備條件, 並考察了藥物所帶電荷對微囊包封率的影響!為微囊的製備提供了有用參數。
特性
離子凝膠薄膜自身具有非常好的柔性和對溶液法的兼容性,所以離子凝膠 OTFT 在柔性電子套用中具有非常廣闊的前景。以離子凝膠作為 OTFT 的柵介電層,一方面引入了非常大的電容,有效地解決了低工作電壓,另一方面由於離子凝膠材料無需用減小厚度的方式來取得大電容,因而其不會成為溶液法製備OTFT 的制約因素,相反離子凝膠可以非常好地集成到溶液法 OTFT 器件當中,從而實現電晶體的低電壓工作。